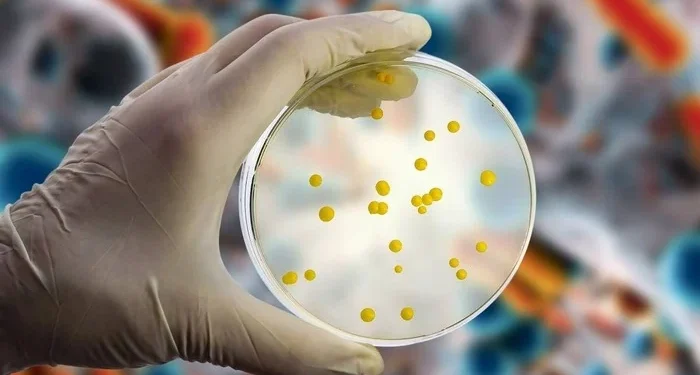
Foto: Getty Images

Quatro casos do fungo Candida auris foram identificados no Hospital João XXIII, em Belo Horizonte, e confirmados pela Secretaria de Estado de Saúde de Minas Gerais (SES-MG) na quarta-feira (16/10). Os casos preocupam porque o fungo possui alta resistência a medicamentos.
Dois dos pacientes infectados tiveram alta nos dias 20 de setembro e 2 de outubro. Os outros dois seguem internados. Outros 24 casos suspeitos estão sendo testados pelo Laboratório Central de Saúde Pública (Lacen) da Fundação Ezequiel Dias (Funed).
Superfungo Candida auris
O Candida auris ficou conhecido como “superfungo”, pois consegue resistir a praticamente todos os medicamentos existentes.Play Video
O primeiro caso de Candida auris em humanos foi identificado no Japão, em 2009. Nos anos seguintes, foram registrados surtos na Índia, África do Sul, Venezuela, Colômbia, Estados Unidos, Reino Unido, Espanha e no Brasil.
Os surtos têm ocorrido em ambientes hospitalares. O maior surto brasileiro ocorreu entre novembro de 2021 e fevereiro de 2022, em um hospital de Recife, em Pernambuco.
O superfungo costuma aparecer em pacientes com a saúde muito frágil que ficam internados em unidades de terapia intensiva (UTI). “As infecções provocadas por ele são, em geral, muito difíceis de tratar porque o fungo é resistente às medicações existentes”, afirmou o professor de imunologia da UnB André Moraes Nicola, em entrevista anterior ao Metrópoles.
O fungo é do mesmo gênero (Candida) do fungo Candida albicans, um dos principais causadores de candidíase, mas as espécies são bem diferentes. A candidíase por C. albicans é uma doença que pode afetar pele, unhas e órgãos genitais, mas é comum e de fácil tratamento. A infecção pelo Candida auris, por sua vez, é resistente a medicamentos e pode ser fatal
É possível ser colonizado de forma passageira pelo C. auris na pele ou na mucosa sem ter problemas. O risco de morte acontece quando o fungo entra na corrente sanguínea, pesquisas apontam um índice de mortalidade de 59% para infecções com C. auris.
O grupo de risco é formado por pessoas que tenham passado por cirurgias, tenham o sistema imunológico comprometido, estejam internados em unidades de terapia intensiva ou tenham feito uso prévio de antibióticos ou antifúngicos.
Como evitar novos casos?
A principal estratégia para evitar surtos é garantir que os hospitais tenham infraestrutura de vigilância para detectar o fungo assim que ele aparecer.
Do ponto de vista individual, a população pode se proteger lavando as mãos com frequência e se certificando de que os equipamentos utilizados nos hospitais são esterilizados.